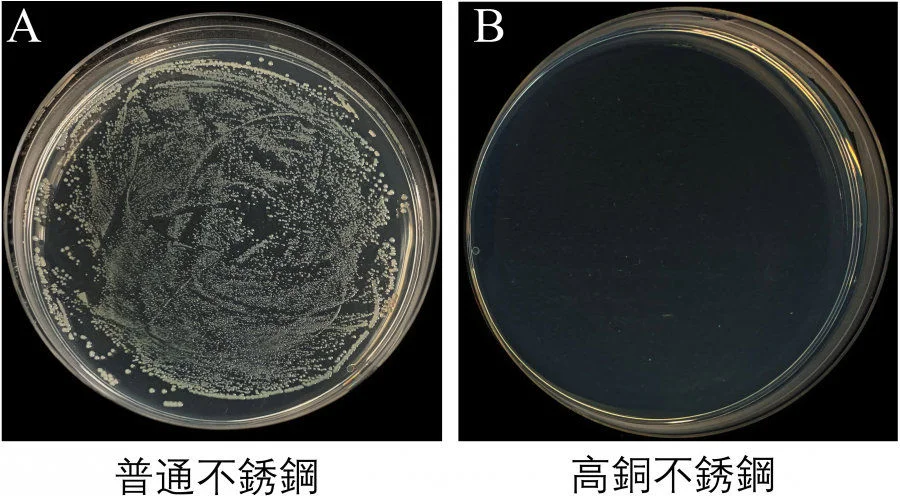
Figure 3. Photos of typical bacterial colonies on A) regular SS and B) the high Cu SS (20 wt%)

The project team led by Professor Mingxin HUANG at the Department of Mechanical Engineering of the Faculty of Engineering of the University of Hong Kong (HKU), in collaboration with Professor Leo Lit Man POON’s research team at the Centre for Immunity and Infection of the LKS Faculty of Medicine of HKU, has made significant breakthroughs in producing the first anti-COVID-19 stainless steel that kills the severe acute respiratory syndrome coronavirus 2 (SARS-Cov-2) on its surface. The anti-COVID-19 stainless steel can also inactivate the H1N1 virus and E.coli on its surface.
The findings were published in Chemical Engineering Journal on 25 November 2021 in the paper titled “Anti-pathogen stainless steel combating COVID-19”.
Stainless steel (SS) is one of the most extensively used materials in many public areas and hygiene facilities but has no inherent antimicrobial properties. Additionally, the SARS-CoV-2 exhibits strong stability on regular SS surfaces, with viable viruses detected even after three days. Undoubtedly, this has created a high possibility of virus transmission among people using these areas and facilities.
“In this latest breakthrough, the inactivation of pathogen microbes (especially the SARS-CoV-2) on SS surface is achieved by tuning the chemical composition and microstructure of regular SS. The breakthrough also found interesting points about Ag and Cu as the allying elements to prepare anti-pathogen SS (Fig. 1~3). Pathogen viruses like H1N1 and SARS-CoV-2 exhibit good stability on the surface of pure Ag and Cu-contained SS of low Cu content (e.g., ≤ 5wt%) but are rapidly inactivated on the surface of pure Cu and Cu-contained SS of high Cu content (e.g., ≥ 10 wt%),” Professor Mingxin Huang said.
A patent (Patent Cooperation Treaty (PCT) type) has been filed for the research findings. The team has been liaising with industrial partners to generate prototypes of public SS products such as lift buttons, doorknobs, and handrails for further tests and trials. For initial demonstration purposes, “floor buttons” used in lifts were fabricated successfully using the high Cu SS (20 wt%) (Fig. 4).
“Massive Cu-rich precipitates are permanently present in the SS matrix. Thus, this anti-COVID-19 SS can chronically inactivate pathogen microbes even though its surface is continuously damaged,” said Mr. Litao LIU, the first author of the journal article and a PhD student supervised by Professor Huang.
“The present anti-COVID-19 SS can be mass produced using existing mature technologies. They can replace some of the frequently touched SS products in public areas to reduce the risk of accidental infection and fight the COVID-19 pandemic,” Professor Huang added.
For the article published in Chemical Engineering Journal.
DOI: 10.1016/j.cej.2021.133783
Media enquiry
Ms Celia Lee, Faculty of Engineering, HKU (Tel: 3917 8519; Email: leecelia@hku.hk) or
Mr Heng Cheng, Faculty of Engineering, HKU (Tel: 3917 1924; Email: hengc@hku.hk)